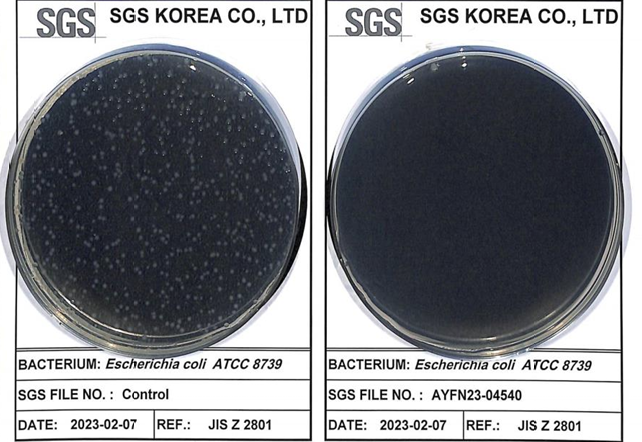
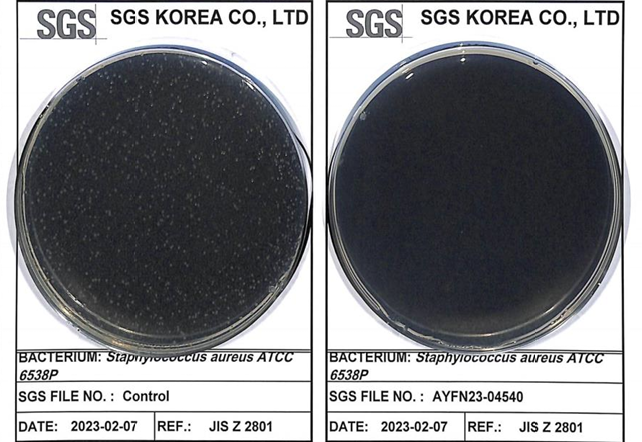

Clinic 의료기


SOFFKIN MEDICAL
Artificial leather for medical facilities
SOFFKIN 의료용 인조가죽
– 전문 의료 환경을 위한 프리미엄 선택
SOFFKIN의 고급 의료용 원단은 병원, 요양원, 클리닉 등
의료 시설에 최적화된 기능성과 내구성을 제공합니다.
제품의 특성
깔끔한 외관과 실용성을 동시에 갖춘
SOFFKIN 인조가죽은 의료 공간의 품격을 높이는 동시에,
환자와 의료진 모두에게 안전하고 쾌적한 환경을 제공합니다.
새롭게 개발된 의료용 코팅 기술을 적용하여 다음과 같은 특징을 갖추고 있습니다.


우수한 항균성
유해균 서식이 불가하도록 항균기능부여
소독제 및 알코올 내성
의료 환경에서 사용되는 다양한 소독제에도 변색이나 손상 없이 견딤
혈액 및 소변 저항성
위생 관리가 중요한 공간에 적합한 소재
유해균으로 부터 보호
각종 유해균 및 바이러스의 서식을 차단해주는
항균 기능으로 건강을 지켜드립니다.
대장균
[Escherichia coli ATCC 8739]
황색포도상구균
[Staphylococcus aureus ATCC 6538P]
우수한 표면기능
의료환경에서 발생할 수 있는
혈액, 각종 약품, 알코올 등에 대한 내성 뿐만 아니라
요양시설에서의 대소변에 의한 오염으로부터
청결이 유지 될 수 있도록 쉽게 청소가 가능합니다.


성적서

